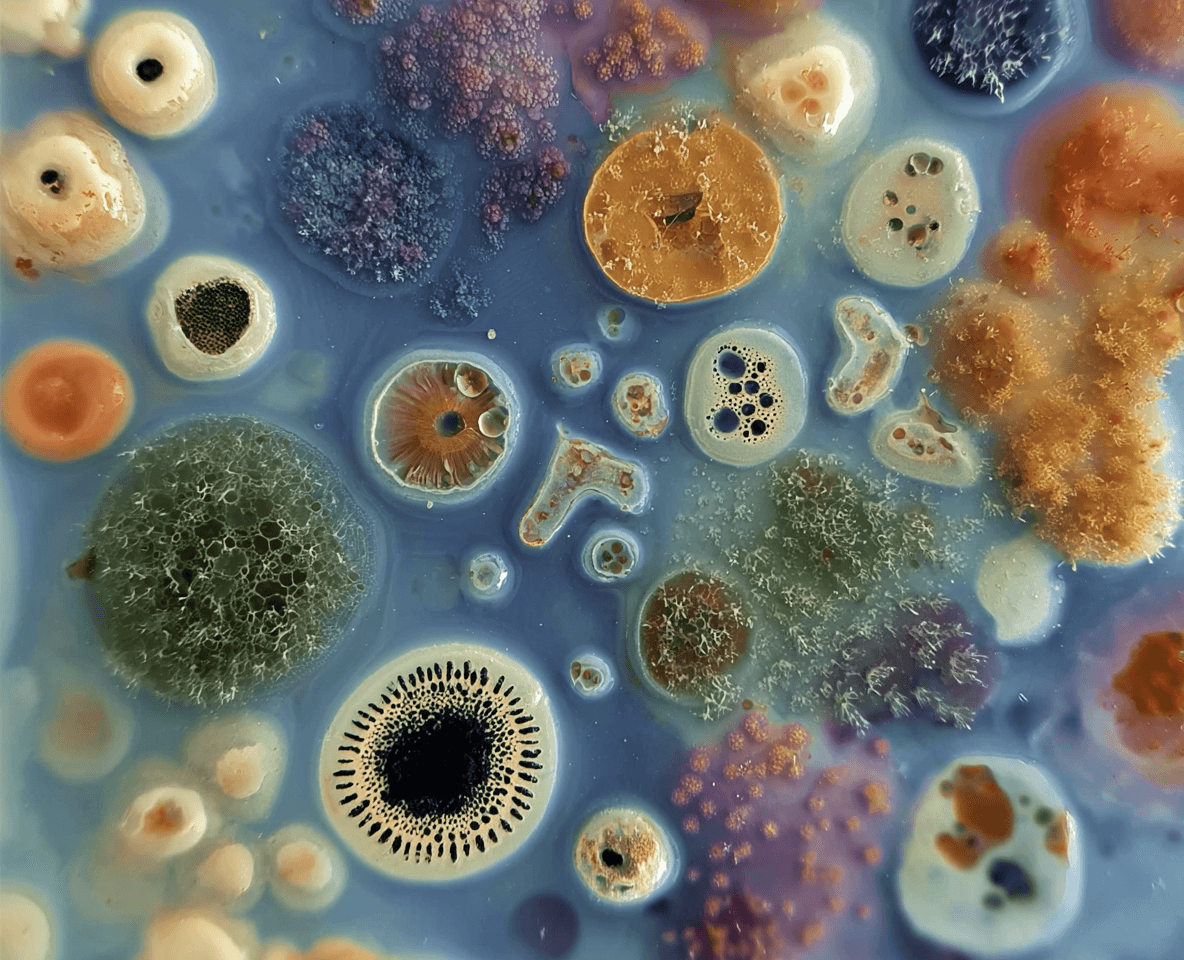

Metagenomic testing
+
Accurate AI analysis
=
Personalized gut health insights you can actually use








We believe healthcare is a right and must be accessible. That’s why our tests are up to 50% cheaper than traditional gut microbiome tests
— without compromising accuracy or depth.
We believe healthcare is a right and must be accessible. That’s why our tests are up to 50% cheaper than traditional gut microbiome tests, without compromising accuracy
Not all microbiome tests are created equal
Not all microbiome tests are created equal
Most only scratch the surface
GutGuru goes deep to understand your entire microbiome ecosystem.
Most only scratch the surface
GutGuru goes deep to understand your entire microbiome ecosystem.




Standard tests
(16S rRNA sequencing)
Coverage
Looks at a small number of bacteria (~100 species)
Detail
Can only tell you general bacteria types
Insights
Very limited

The GutGuru test
(metagenomic sequencing)
Coverage
Looks at everything in your gut - 1000+ species including bacteria, viruses, fungi, and parasites
Detail
Pinpoints exact strains for precise, personalised insights
Insights
Complete view of your gut ecosystem so we can give advice that really works for YOU
We go even further..
We go even further..

Most gut tests rely only on western data

Most gut tests rely only on western data

Most gut tests rely only on western data
GutGuru combines global research with our own studies on Eastern populations to deliver results that are truly culturally relevant and specific
GutGuru combines global research with our own studies on Eastern populations to deliver results that are truly culturally relevant and specific


Lifestyle + nutrition guidance
Lifestyle + nutrition guidance
Lifestyle + nutrition guidance
What you can find out from testing your gut
GI Health
How well you digest, absorb nutrients and sustain energy


Immune Health
Your gut lining is the first line of defense as it house 70% of immune cells, we look at how your gut regulates inflammation and immune defense


Brain & Mental health
How gut–brain signaling affects stress, focus, and emotional balance. The gut is one of the sites of neurotransmitter production and it’s where about 95% of total serotonin is found


Immune Health
Your gut lining is the first line of defense as it house 70% of immune cells, we look at how your gut regulates inflammation and immune defense


Brain & Mental health
How gut–brain signaling affects stress, focus, and emotional balance. The gut is one of the sites of neurotransmitter production and it’s where about 95% of total serotonin is found


Metabolic Health
How your body manages blood sugar, weight, and metabolic efficiency


Metabolic health
How your body manages blood sugar, weight, and metabolic efficiency


GI Health
How well you digest, absorb nutrients and sustain energy


Immune Health
Your gut lining is the first line of defense as it house 70% of immune cells, we look at how your gut regulates inflammation and immune defense


GI Health
How well you digest, absorb nutrients and sustain energy


Immune Health
Your gut lining is the first line of defense as it house 70% of immune cells, we look at how your gut regulates inflammation and immune defense


Brain & Mental health
How gut–brain signaling affects stress, focus, and emotional balance. The gut is one of the sites of neurotransmitter production and it’s where about 95% of total serotonin is found


Metabolic Health
How your body manages blood sugar, weight, and metabolic efficiency


Metabolic health
How your body manages blood sugar, weight, and metabolic efficiency


How it works


1. Test your gut microbiome
Your at-home stool test is delivered to your doorstep. You collect your sample, and we handle the rest — secure pickup and lab analysis using metagenomic sequencing


1. Test your gut microbiome
Your at-home stool test is delivered to your doorstep. You collect your sample, and we handle the rest — secure pickup and lab analysis using metagenomic sequencing


2. Understand how your gut impacts the rest of your body
We turn complicated data into clear insights. Your digital dashboard shows your results and how your gut impacts key body systems- including mental health, metabolism, hormones, immunity, skin, and energy - with easy-to-understand results and priority focus areas


2. Understand how your gut impacts the rest of your body
We turn complicated data into clear insights. Your digital dashboard shows your results and how your gut impacts key body systems- including mental health, metabolism, hormones, immunity, skin, and energy - with easy-to-understand results and priority focus areas


3. Get a personalized, actionable health plan
Based on your gut profile, we create a tailored plan designed for real life. This includes: Personalized nutrition guidance, lifestyle and habit recommendations, targeted supplement support (only where needed)


3. Get a personalized, actionable health plan
Based on your gut profile, we create a tailored plan designed for real life. This includes: Personalized nutrition guidance, lifestyle and habit recommendations, targeted supplement support (only where needed)


4. Ongoing guidance and expert care
You’re not left to figure it out alone. Your AI gut coach provides personalised answers, guidance, and check-ins based on your data. You also get access to our trusted network of gastroenterologists and nutritionists whenever expert support is needed


4. Ongoing guidance and expert care
You’re not left to figure it out alone. Your AI gut coach provides personalised answers, guidance, and check-ins based on your data. You also get access to our trusted network of gastroenterologists and nutritionists whenever expert support is needed
How it works


1. Test your gut microbiome
Your at-home stool test is delivered to your doorstep. You collect your sample, and we handle the rest — secure pickup and lab analysis using metagenomic sequencing


1. Test your gut microbiome
Your at-home stool test is delivered to your doorstep. You collect your sample, and we handle the rest — secure pickup and lab analysis using metagenomic sequencing


2. Understand how your gut impacts the rest of your body
We turn complicated data into clear insights. Your digital dashboard shows your results and how your gut impacts key body systems- including mental health, metabolism, hormones, immunity, skin, and energy - with easy-to-understand results and priority focus areas


2. Understand how your gut impacts the rest of your body
We turn complicated data into clear insights. Your digital dashboard shows your results and how your gut impacts key body systems- including mental health, metabolism, hormones, immunity, skin, and energy - with easy-to-understand results and priority focus areas


3. Get a personalized, actionable health plan
Based on your gut profile, we create a tailored plan designed for real life. This includes: Personalized nutrition guidance, lifestyle and habit recommendations, targeted supplement support (only where needed)


3. Get a personalized, actionable health plan
Based on your gut profile, we create a tailored plan designed for real life. This includes: Personalized nutrition guidance, lifestyle and habit recommendations, targeted supplement support (only where needed)


4. Ongoing guidance and expert care
You’re not left to figure it out alone. Your AI gut coach provides personalised answers, guidance, and check-ins based on your data. You also get access to our trusted network of gastroenterologists and nutritionists whenever expert support is needed


4. Ongoing guidance and expert care
You’re not left to figure it out alone. Your AI gut coach provides personalised answers, guidance, and check-ins based on your data. You also get access to our trusted network of gastroenterologists and nutritionists whenever expert support is needed